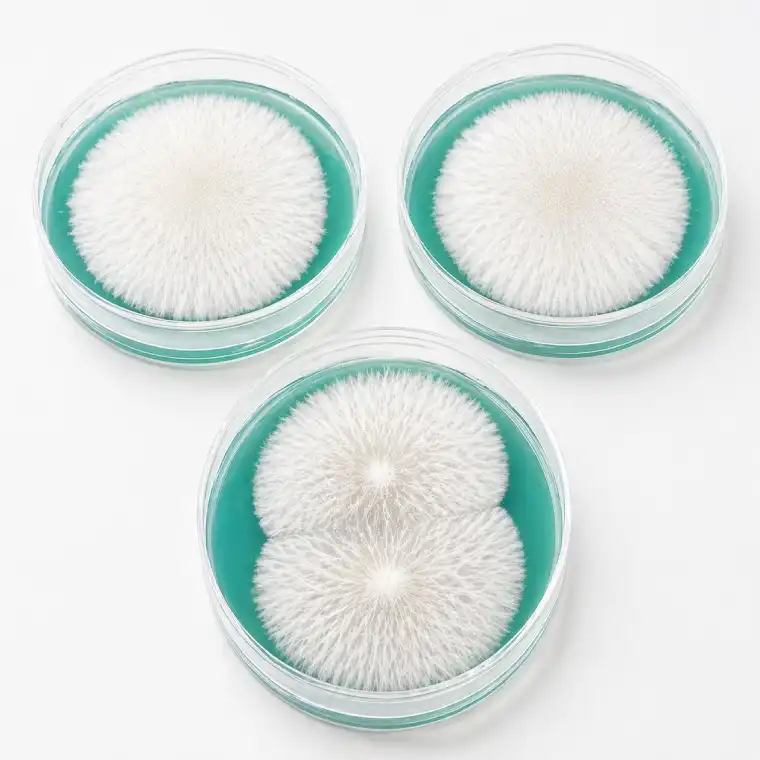

SporeAura Blue Smurf LME Agar Plates – Premium Sterile Agar for Precision Mycology
Mushroom grow bags and agar plates are essential tools in modern mycology, and SporeAura Blue Smurf LME Agar Plates are expertly developed to deliver fast, clean, and consistent results. Built for performance, these sterile agar plates for mushroom cultivation (90 × 15.7 mm) provide a controlled, contamination-resistant environment that promotes strong, rhizomorphic mycelium growth from the very start.
Formulated using an advanced Light Malt Extract (LME) recipe, this nutrient-rich medium supports rapid colonisation and reliable spore germination, making it a trusted choice within professional mycology supplies and cultivation equipment.
Why Choose Light Malt Extract (LME)?
SporeAura LME Agar Plates are precision-prepared, pre-poured petri dishes containing a balanced blend of light malt extract and agar. This high-performance mushroom substrate alternative provides essential nutrients for fungal development while maintaining a stable, sterile structure.
- Encourages faster colonisation and healthy growth
- Supports consistent and predictable results
- Creates a contamination-resistant environment
Key Benefits
- Pre-Sterilised & Ready to Use – Save time with professionally prepared plates
- Nutrient-Dense Formula – Optimised for vigorous mycelium development
- Stable & Clean Environment – Designed to reduce contamination risks
- Professional-Grade Quality – Reliable results across multiple applications
- Versatile Use – Suitable for fungi, yeasts, and mould cultures
Designed for Mycology & Cultivation Excellence
As part of SporeAura’s premium mycology supplies, these agar plates are ideal for isolating cultures, selecting strong genetics, and refining cultivation techniques. Whether used alongside mushroom grow bags or other cultivation equipment, they provide the precision and control needed for successful outcomes.
How to Use
- Inoculate the agar plate with your spore or tissue sample
- Seal and incubate under suitable conditions
- Observe visible mycelial growth within days
The Blue Smurf LME formula is specifically engineered to accelerate colonisation, delivering faster and healthier development.
Applications
- Spore germination and culture initiation
- Fungal strain isolation and genetic selection
- Mycelium growth observation
- Research and microscopy work
SporeAura Standard
At SporeAura, we prioritise sterility, quality, and performance across all mycology supplies. Our Blue Smurf LME Agar Plates are manufactured to meet high standards, ensuring consistency and reliability in every use.

Reviews
There are no reviews yet.